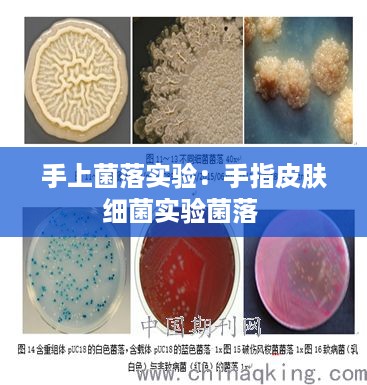

实验背景与目的
手上菌落实验是一种常见的微生物学实验,旨在了解和检测人体皮肤上的微生物种类和数量。随着人们对健康和卫生问题的关注度不断提高,了解手部菌落对于预防疾病传播、保持个人卫生具有重要意义。本实验旨在通过采集手部样本,培养和观察菌落,分析手部菌落的种类和数量,从而提高人们对个人卫生的认识。
实验材料与工具
为了进行手上菌落实验,我们需要以下材料和工具:
- 无菌棉签
- 无菌培养皿
- 营养琼脂培养基
- 酒精灯
- 无菌镊子
- 显微镜
- 记号笔
- 计时器
实验步骤
以下是手上菌落实验的具体步骤:
- 将无菌棉签插入酒精灯火焰中,待棉签燃烧至红热状态。
- 待棉签冷却后,在实验者的手部不同部位(如手掌、手指、手背)轻轻擦拭,以采集菌落。
- 将采集到的菌落涂抹在无菌培养皿的营养琼脂培养基表面。
- 将培养皿放入37℃恒温培养箱中,培养24小时。
- 观察培养皿上的菌落生长情况,记录菌落数量和形态。
- 使用无菌镊子将菌落移至显微镜载玻片上,滴加适量水,盖上盖玻片。
- 在显微镜下观察菌落形态,记录菌落种类。
实验结果与分析
通过实验,我们可以观察到以下结果:
- 手部菌落数量较多,不同部位的菌落数量存在差异。
- 菌落形态多样,包括球菌、杆菌、丝状菌等。
- 手掌部位的菌落数量最多,手指和手背部位的菌落数量相对较少。
分析实验结果,我们可以得出以下结论:
- 手部是人体皮肤上菌落数量最多的部位,这与手部经常接触外界环境有关。
- 不同部位的菌落数量差异可能与手部接触物体的种类和频率有关。
- 菌落形态的多样性表明手部菌落种类丰富,可能与人体皮肤上的微生物生态平衡有关。
实验总结与展望
手上菌落实验是一种简单易行的微生物学实验,通过本实验,我们可以直观地了解手部菌落的种类和数量,提高人们对个人卫生的认识。以下是对实验的总结和展望:
- 实验结果表明,手部是人体皮肤上菌落数量最多的部位,因此保持手部清洁对于预防疾病传播至关重要。
- 实验过程中,应注意无菌操作,避免污染样本和培养皿。
- 未来可以进一步研究不同人群手部菌落的差异,以及手部菌落与疾病传播的关系。
- 此外,可以结合分子生物学技术,对菌落进行更深入的分类和鉴定。
总之,手上菌落实验是一种具有实际应用价值的实验,通过实验我们可以更好地了解手部菌落,提高个人卫生意识,为预防疾病传播提供科学依据。
转载请注明来自无忧安证,本文标题:《手上菌落实验:手指皮肤细菌实验菌落 》
百度分享代码,如果开启HTTPS请参考李洋个人博客

蜀ICP备2022005971号-1
还没有评论,来说两句吧...